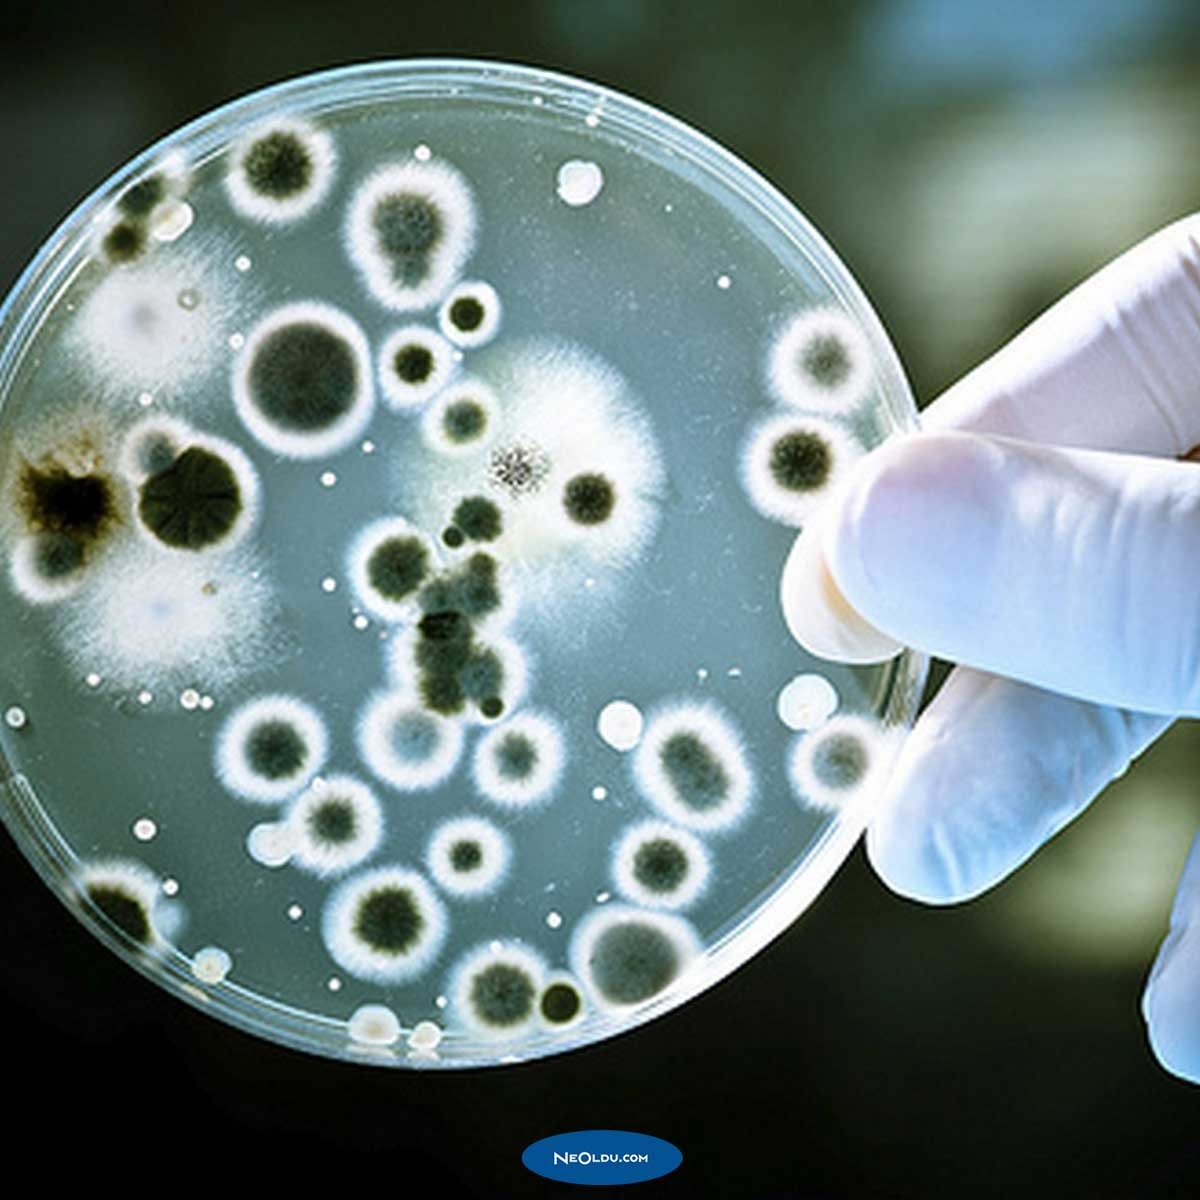

Pandemi, Epidemi ve Endemi Arasındaki Fark Nedir?
COVID-19, Dünya Sağlık Örgütü tarafından küresel bir salgın ilan edilmişti. Peki bu ne anlama geliyor? Pandeminin epidemi ve endemiden farkı nedir? İşte sıkça karıştırılan terimlerin anlamları..
Dünya Sağlık Örgütü (DSÖ), SARS-CoV-2 virüsünden kaynaklanan salgının alışılmadık derecede hızlı olmasından dolayı COVID-19'u pandemi olarak ilan etti. Ortaya çıkışından kısa bir süre sonra tüm dünyayı etkisi altına alan yeni koronavirüs, dünya çapında 1.300.000'den fazla insanı enfekte ederken 200'den fazla ülkede 76.000'den fazla kişinin hayatını kaybetmesine sebep olmuştur. Küresel ölüm oranı %4.4 olan yeni koronavirüsün pandemi ilan edilmesi ne anlama geliyor? İnsanların sıklıkla karıştırdığı pandemi, epidemi ve endemi arasındaki farklar...
Pandemi, Epidemi (Salgın) ve Endemi Arasındaki Fark Nedir?

Bazı insanlar "salgın", "pandemi" ve "epidemi" terimlerini birbirinden ayırt etmekte zorlanmaktadır. Birçok kez her bu üç terimde birbirinin yerine kullanılırken bu terimlerin farklı anlamları bulunmaktadır. Salgın, kontrolden çıkmış bir hastalığı veya sorunu tanımlamak için kullanılan bir terimdir. Tıbbi olarak herhangi bir salgın belirli bir toplumda belirli bir zamanda ortaya çıkan yaygın hastalık olarak tanımlanmaktadır. Pandemi ise herhangi bir enfeksiyon veya hastalık yaşayan kişilerin sayısının bir ülkeyi, kıtayı hatta tüm dünyayı etkisi altına alması anlamına gelmektedir. Endemi, belirli bir alanda veya belirli bir popülasyon arasında tahmin edilebilir bir oranda meydana gelen salgın hastalıklardır.
Herhangi bir hastalık ülke sınırlarının ötesine yayıldığında ve aynı anda farklı ülkeler arasında yaygınlaştığında bu salgın pandemi haline gelmektedir. Dünya Sağlık Örgütü tarafından ilan edilen pandemi, WHO'ya göre "yeni bir hastalığın dünya çapında yayılması" olarak tanımlamaktadır. Diğer bir deyişle pandemi, birçok ülkeye yayılmış ve genellikle çok sayıda insanı etkileyen bir hastalık anlamına gelmektedir. Pandemi terimi Eski Yunanca'da "tüm insanlar" anlamına gelen "pan" ve "demos" kelimelerinden türetilmiştir. Bu bakımdan her pandemi bir salgındır ancak her salgın bir pandemi değildir. Pandeminin epidemi yani salgından en büyük farkı:
Pandemi çok sayıda insanı enfekte ederek hayati risk oluşturmaktadır.
Pandemi genellikle dünya çapında daha geniş coğrafi bölgeleri etkisi altına almaktadır.
Pandemiler genellikle sosyal bozulmalara, ekonomik kayıplara ve ülkesel sıkıntılara yol açabilir.
Pandemi ilan edilen olaylar epidemilere göre daha hızlı yayılır ve daha fazla ölüme neden olmaktadır.
Pandemi vakalarında genellikle insanların yeni çıkan virüse karşı bağışıklığı çok zayıftır veya hiç yoktur.
Pandemi genellikle uzun süredir insanlarda görülmeyen veya yeni ortaya çıkmış virüslerden kaynaklanmaktadır.
Pandemi Nedir?
 Pandemi, yeni bir bulaşıcı hastalığın dünya çapında yayılmasıdır. Bu kelime Yunancadan türetilmiştir. Pandemiler genellikle daha geniş olanlara yayılarak insanları enfekte etmektedir ve daha fazla ölüme neden olmaktadır. Tüm bunların yanında pandemi terimi salgının ölümcüllüğünü değil hastalığın yayılma şiddetini ifade etmek için kullanılmaktadır. Tarih boyunca birbirinden farklı pandemi vakaları yaşanmıştır ve milyonlarca insan hayatını kaybetmiştir.
Pandemi, yeni bir bulaşıcı hastalığın dünya çapında yayılmasıdır. Bu kelime Yunancadan türetilmiştir. Pandemiler genellikle daha geniş olanlara yayılarak insanları enfekte etmektedir ve daha fazla ölüme neden olmaktadır. Tüm bunların yanında pandemi terimi salgının ölümcüllüğünü değil hastalığın yayılma şiddetini ifade etmek için kullanılmaktadır. Tarih boyunca birbirinden farklı pandemi vakaları yaşanmıştır ve milyonlarca insan hayatını kaybetmiştir.
Epidemi (Salgın) Nedir?

Salgın, belli bir alanda beklenenden daha fazla insanın hastalanmasına sebep olan vakalara verilen genel bir isimdir. Genellikle küçük bir topluluk arasında olabileceği gibi ülke genelinde hatta birkaç ülkede yaşanabilmektedir. Salgınlar genellikle birkaç gün sürebileceği gibi haftalarca hatta yıllarca devam edebilmektedir. Öte yandan salgınlar kişiden kişiye temas, hayvandan insana temas yoluyla veya çevresel faktörlere bağlı olarak bulaşabilmektedir.
Endemi Nedir?
Bir pandeminin oluşumuna sebebiyet veren şey genellikle insanlar arasında kolayca bulaşabilen yeni bir virüs, virüsün alt tipi veya antibiyotiklerle tedaviye dirençli olan bakteriler neden olmaktadır. Hızla yayılım göstererek belli bir kıtayı ya da tüm dünyayı etkisi altına alabilen pandemi, tarih boyunca milyonlarca insanın ölümüne sebebiyet vermiştir. Pandemi tarihine yakından bakıldığında 14. yüzyılda (1347-1351) Avrupa'da ortaya çıkan ve büyük bir yıkıma sebep olan Kara Ölüm bir diğer adıyla Büyük Veba Salgını akıllara gelmektedir. Bu salgının tahmini olarak yalnızca 14. yüzyılda yaklaşık 200 milyon kişinin ölümüne neden olduğu söylenmektedir.
Yapılan araştırmalar insanların yeni bir virüse karşı çok az bağışıklığının olabileceğini veya hiç bağışıklığının olmayacağını göstermektedir. Pandemik olaylar genellikle yeni bir virüsün mutasyon geçirerek insandan insana yayılmasıyla ortaya çıkmaktadır. Bu durum yeni bir virüsün kişiden kişiye kolayca yayılmasından çok virüsün mutasyona uğraması sonucu yayıldığını göstermektedir. Böylelikle pandemiler bir salgından daha fazla insanı etkileme eğilimindedir ve daha ölümcül sonuçlar doğurabilmektedir. Öte yandan pandemiler sosyal bozulmalara, ekonomik kayıplara ve ülkesel sıkıntılara yol açabilir.

Bir pandeminin oluşumuna sebebiyet veren şey genellikle insanlar arasında kolayca bulaşabilen yeni bir virüs, virüsün alt tipi veya antibiyotiklerle tedaviye dirençli olan bakteriler neden olmaktadır. Hızla yayılım göstererek belli bir kıtayı ya da tüm dünyayı etkisi altına alabilen pandemi, tarih boyunca milyonlarca insanın ölümüne sebebiyet vermiştir. Pandemi tarihine yakından bakıldığında 14. yüzyılda (1347-1351) Avrupa'da ortaya çıkan ve büyük bir yıkıma sebep olan Kara Ölüm bir diğer adıyla Büyük Veba Salgını akıllara gelmektedir. Bu salgının tahmini olarak yalnızca 14. yüzyılda yaklaşık 200 milyon kişinin ölümüne neden olduğu söylenmektedir.
Yapılan araştırmalar insanların yeni bir virüse karşı çok az bağışıklığının olabileceğini veya hiç bağışıklığının olmayacağını göstermektedir. Pandemik olaylar genellikle yeni bir virüsün mutasyon geçirerek insandan insana yayılmasıyla ortaya çıkmaktadır. Bu durum yeni bir virüsün kişiden kişiye kolayca yayılmasından çok virüsün mutasyona uğraması sonucu yayıldığını göstermektedir. Böylelikle pandemiler bir salgından daha fazla insanı etkileme eğilimindedir ve daha ölümcül sonuçlar doğurabilmektedir. Öte yandan pandemiler sosyal bozulmalara, ekonomik kayıplara ve ülkesel sıkıntılara yol açabilir.
İnsanlar pandemik bir vakanın ortaya çıkmasından ve yayılmasının ardından bu virüse karşı bağışıklık geliştirebilmektedir. ancak bunun zaman alan bir süreç olduğu bilinmektedir. Aynı zamanda pandemik olaya sebebiyet veren virüsün alt tipleri birkaç yıl boyunca insanlar arasında dolaşabilir ve ara sıra salgınlara (örneğin influenza) yol açabilmektedir. Başta Dünya Sağlık Örgütü (WHO) olmak üzere çeşitli kurumlar salgının kontrol altına alınabilmesi için virüslerin hareketlerini ve davranışlarını yakından izlemektedir.
Corona Virüsü Pandemisi Nedir?

COVID-19 olarak da bilinen yeni koronavirüs 11 Mart 2020 tarihinden Dünya Sağlık Örgütü (WHO) tarafından pandemi ilan edilmiştir. DSÖ Genel Müdürü olağan medya brifinginde, DSÖ'nün bu salgını 24 saat boyunca değerlendirdiğini, endişe verici yayılma ve ciddiyet seviyesi ve endişe verici eylemsizlik seviyeleri ile derinden endişelendiklerini belirtmiştir. Bu nedenle DSÖ COVID-19'un bir pandemi olarak nitelendirilebileceği değerlendirmesini yapmıştı. 2019 yılının son çeyreğinde ortaya çıkan ve tüm dünyayı etkisi altına alan COVID-19 hakkında detaylı bilgi için Koronavirüs Nasıl Yayılır? adlı içeriğe göz atabilirsiniz.
DSÖ Genel Direktörü Dr. Tedros Adhanom Ghebreyesus yaptığı açıklamada: "Pandemi hafif veya dikkatsizce kullanılacak bir kelime değildir. Yanlış kullanılırsa mantıksız bir korkuya, gereksiz acıya ve ölüme yol açabilecek bir kelimedir. Durumu bir pandemi olarak tanımlamak DSÖ'nün bu koronavirüsün yarattığı tehdit hakkında değerlendirmesini değiştirmez. Aynı şekilde DSÖ'nün yaptığı şeyi ve ülkelerin ne yapması gerektiğini değiştirmez." ifadelerini kullanmıştı. 10 Mart'ta IFRC, UNICEF ve DSÖ, çocukları ve okulları COVID-19 virüsünün bulaşmasından korumaya yardımcı olmak için yeni bir rehber yayınlamıştı. Rehber, okulları güvende tutmak için kritik hususlar ve pratik kontrol listeleri sağlamaktadır.
COVID-19 Neden Pandemi İlan Edildi?

andemik vakalar, dünya üzerinde birçok farklı toplumu, kıtayı hatta tüm dünyayı etkileyen ve insan sağlığını tehlike altına genel bir alarm durumudur. Dünya Sağlık Örgütü (WHO), yakın zamanda ortaya çıkan ve SARS-CoV-2 virüsünün sebep olduğu COVID-19 enfeksiyonunu dünya çapında pandemi olarak ilan etmişti. COVID-19'un neden pandemi ilan edildiğine yakından bakacak olursak , temel amacın ulusal ve küresel alandaki halk sağlığı kurumlarının bu salgına karşı daha yüksek düzeyde önlemler almasını sağlamak olduğu görülmektedir.
Bir başka deyişle COVID-19'un pandemi olarak ilan edilmesinin temel sebebi toplumda panik ve kargaşaya yol açmak değil, ülkelerin bu konuda bilinçli davranması gerektiğini hatırlatmaktır. Öte yandan pandemi ibaresinin kullanımı aynı zamanda salgını kontrol altına almaya çalışan ülkelerin birlikteliğini vurgulamaktadır.
Tarihin En Acı Pandemileri

1918'den 1920'ye kadar 100 milyon insanın hayatını kaybetmesine sebep olan İspanyol Gribi, tarihin en kötü pandemisi olarak kabul edilmektedir. Dünya tarihinde yaşanmış en korkunç pandemik vakalar hakkında detaylı bilgi için Dünyanın En Ölümcül 10 Salgını adlı içeriğine göz atabilirsiniz.
Justinianus Veba Salgını: 541-542 yılları arasında ortaya çıkan bu pandemi, Bizans İmparatorluğu başta olmak üzere Konstantinopolis, Sasani İmparatorluğu ve Akdeniz etrafında bulunan liman şehirlerini etkilemiştir. Tarihin en büyük veba salgınlarından biri olarak bilinen bu olay, toplamda 50 milyon insanın ölümüne sebep olmuştur.
Kara Ölüm: 1347-1351 yılları arasında ortaya çıkan bu pandemi, Asya'nın güney batısında başlayarak Avrupa'ya kadar ulaşmıştır. Yersinia pestis adı verilen bir bakterinin yol açtığı bu olay, tarihin en acı veba salgınlarından bir tanesidir. Kara Ölüm pandemisi sonucunda dünyada 200 milyona yakın insan hayatını kaybetmiştir.
Altıncı Kolera Salgını: 1899-1923 yılları arasında ortaya çıkan bu pandemi, Hindistan'dan başlayarak Orta Doğu, Kuzey Afrika, Doğu Avrupa ve Rusya'ya kadar ulaşan büyük bir kolera salgınıdır. Bu pandemi sonucunda dünyada 800.000'den fazla insan hayatını kaybetmiştir.
İspanyol Gribi: 1918-1920 yılları arasında ortaya çıkan bu pandemi, ortaya çıkışından kısa bir süre sonra 500 milyondan fazla kişiyi enfekte etmiştir. Salgının başlamasından kısa bir süre sonra toplamda 50-140 milyon arasında insan hayatını kaybetmiştir.
Hong Kong Gribi: 1968-1969 yılları arasında ortaya çıkan bu pandemi, A tipi H3N2 virüsünün sebep olduğu bir çeşit grip salgınıdır. Antijenik sapma nedeniyle H2N2 virüsünden türeyen bu virüs, dünya üzerinde ortalam 1.000.000 insanın ölümüne sebep olmuştur.
Kaynak: .neoldu.com




Yorumlar
Yorumları Göster Yorumları Gizle